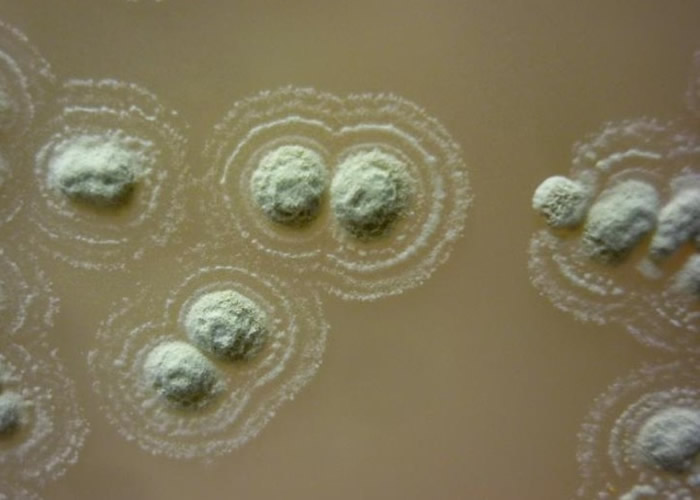
英国斯旺西大学医学院团队分析北爱尔兰古老土壤发现新种菌株 有效抑制超级病菌

英国斯旺西大学医学院团队分析北爱尔兰古老土壤发现新种菌株 有效抑制超级病菌
英国斯旺西大学医学院团队分析北爱尔兰古老土壤发现新种菌株 有效抑制超级病菌
(蜘蛛网eeook.com报道)人类滥用抗生素,产生了不少具抗药性的超级病菌,令医学界极为苦恼。英国有大学团队分析北爱尔兰一些古老土壤,从中发现一种不为人知的菌株,能抑制包括耐药性金黄葡萄球菌等4种超级病菌。
英国斯旺西大学医学院的国际研究团队,知悉弗马纳郡的波霍高地(Boho Highlands)的居民,传统会把小量当地的土壤包上棉布,用来治疗牙痛、颈部感染等症状。研究人员于是分析该些属硷性的土壤,结果发现含有一种新的链霉菌菌株,对已被世界卫生组织(WHO)确认的6大耐药性病菌中的4种,能产生抑制作用。
团队目前尚未清楚,菌株中的甚么成分能抑制超级病菌生长,仍在研究查证。大学教授戴森(Paul Dyson)认为,是次研究证明民间及传统医学值得深入研究,以助找出解决细菌对抗生素产生抗药性的问题。